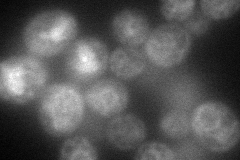
YMR020W
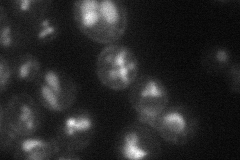
YMR020W
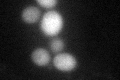
YMR020W
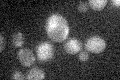
YMR020W
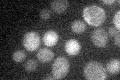
YMR020W

View description
Polyamine oxidase, converts spermine to spermidine, which is required for the essential hypusination modification of translation factor eIF-5A; also involved in pantothenic acid biosynthesis
Localization:
Intensity:
Fold change:
Significance:
-
C’ GFP library in SD

cytosol22.26 -
N' NOP1pr-GFP in SD
ER79.469 -
N' TEF2pr-mCherry in SD
vacuole20.6882 -
N' NATIVEpr-GFP in SD

below threshold21.4856 -
N' TEF2pr-VC and Cyto-VN in SD

#N/A0 -
C’ GFP library in SD+DTT
cytosol32.31.45Yes -
C’ GFP library in SD+H2O2
cytosol22.20.99No -
C’ GFP library in Starvation Media
cytosol25.421.14No -
C’ GFP library on the background of Pup2-DaMP

cytosol -
C’ GFP library on the background of CCT mutant

cytosol21.32110.957427No
